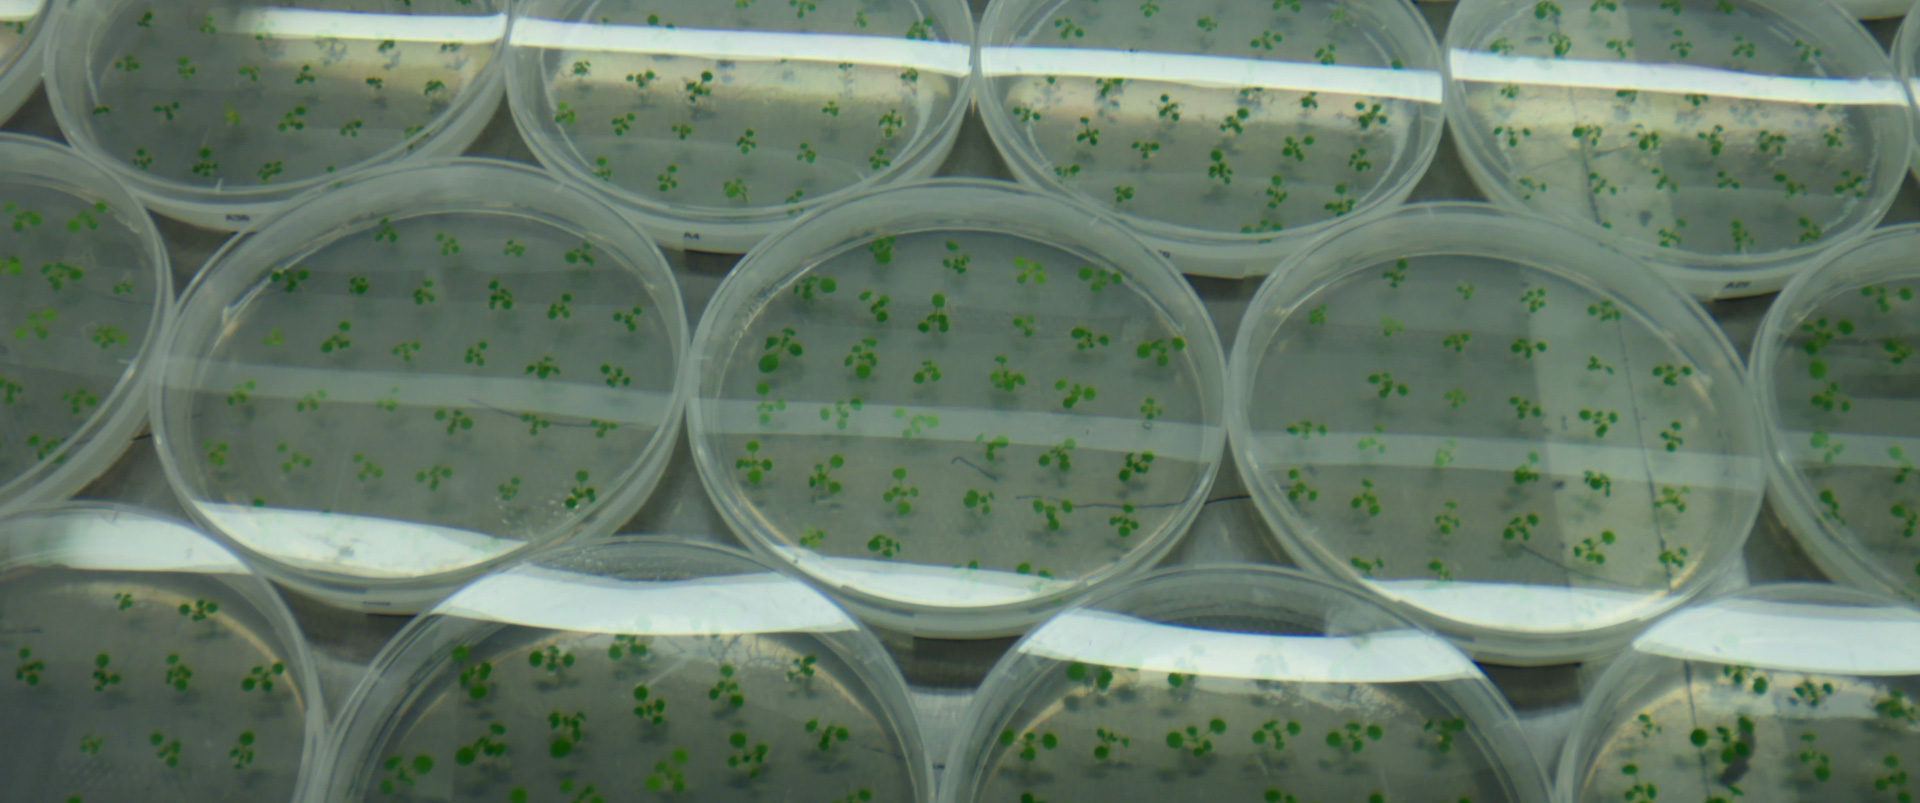

The DNA Revolution
Synopsis
The decoding of the human genome and breakthroughs such as CRISPR-Cas offer new hope for treating and even preventing diseases such as cancer and Alzheimer’s. Yet the ability to manipulate our DNA also raises profound ethical questions. What becomes of the individual when everything about us can be known—or engineered? Privacy versus health, collective good versus personal freedom.
Emerging research suggests our DNA influences us far more than we realise—even shaping our personality. This opens doors to extraordinary possibilities, but also to alarming risks, including the spectre of a “Big Brother” future.
The story extends beyond medicine: agriculture and food are just as deeply affected. We explore the laws governing food technology, the limits of genetic engineering, and the impact on biodiversity—from genetically modified crops to lab-grown meat.
At the frontier, scientists are designing DNA from viruses, bacteria, and entire microbiomes, and creating synthetic molecules with no natural counterpart—pushing humanity into a God-like role. Combined with artificial intelligence, these innovations make the potential of the DNA revolution virtually limitless, constrained only by imagination.
A four-part series exploring the immense promise—and the profound dangers—of the DNA revolution.
WATCH THE SERIES ON VRT MAX: https://www.vrt.be/vrtmax/a-z/dna/
Credits
- Scenario: Maarten Stuyck
- Producenten: Maarten Bernaerts, Barbara Dyck, Bram Conjaerts
- Regie: Maarten Stuyck, Lennart Stuyck, Ruben Vermeersch
- Montage: Jason Boënne, Kwinten Gernay
- Montage assistent: Michiel Zeguers
- Camera: Adrien Lengrand, Tom Gineyts, Quintin Devillers, Matthieu Fabri, Benjamin Morel, Steven Heyvaert, Son Doan
- Geluid: Maarten Bernaerts
- Klankmontage en mix: Hugo Hermans
- Voice over: Annelies Moons
- Voice over opname: Thomas Resimont
- Beeld postproductie: Sondr
- Grafiek en animatie: Annelies Vaes